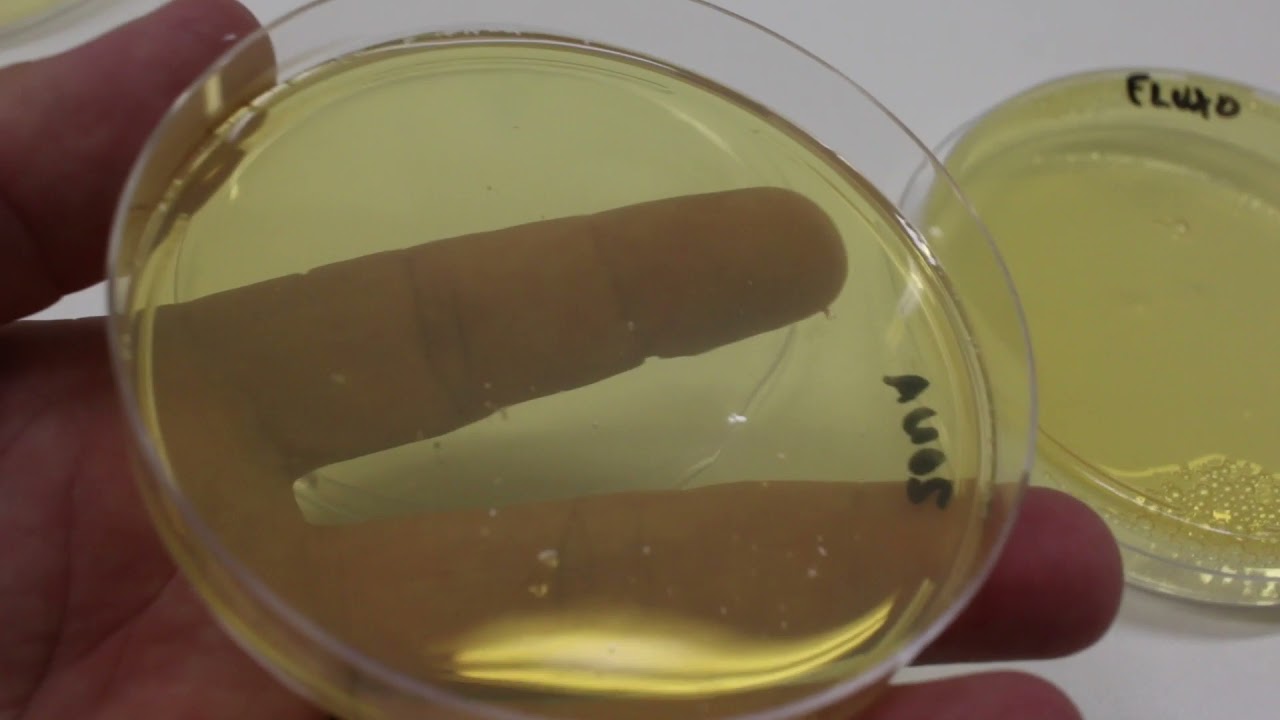
Aula Pratica 1 -  RESULTADO - Material e técnicas utilizadas no laboratório de Microbiologia

O Olá pessoal uma alegria está de volta para falar sobre um assunto que eu gosto demais da conta que é sobre micorrizas com a aula de hoje ela tem um conteúdo ela ativamente conciso mas que a gente vai explorar de uma forma bem interessante eu quero falar hoje para vocês sobre os tipos de me corrigir esses o benefício dessa interação os fatores que controlam a associação do tipo incorrido o potencial Biotecnológico que existe nessa associação e a gente vai trazer alguns estudos de casos para a gente entender um pouco mais esse conceito que eu tô
trazendo para vocês hoje que é uma coisa que eu quero com certeza que fica fixado para o resto da vida de vocês tem uma coisa muito bonita e muito interessante e quem sabe vai ser ainda muito explorado de uma e tecnológica no futuro ainda mais do que hoje legal a gente sabe né Vou te Aviso e vocês sabem que os fungos do solo eles são os seres unipresentes né gente sabe que todo só não está carregado de fundo eles assim se encontra um desde solos mais desérticos a solos Tropicais em grandes quantidades nem termos de
biomassa estão ali juntinho com as bactérias é claro que em termos de número de células eles estão em menor abundância mais internas de biomassa eles equalizam bem ele com as bactérias E eles estão variando desde uma relação é super benéfica para as plantas não onde a gente está colocando eles como simbiontes até uma relação que apesar de eu ter colocado aqui no posto Na verdade é um outro tipo de simbiose é uma simbiose mais né é uma simbiose negativa onde ao invés de lhe fazer uma relação positiva com a planta ele causa um no processo
negativo e a gente tá falando aqui dos patógenos dentro a gente tem várias doenças causadas por fungos que São fitopatógenos E então os fungos estão oscilando aí entre elementos muito positivos sobre um viés de promoção de crescimento vegetal até um viés muito negativo onde a gente está trabalhando você então patógenos e entre esses dois nós queremos né sobre uma uma visão antropocêntrica a gente tem aqueles que estão simplesmente é trabalhando no funcionamento do ecossistema ali por exemplo na ciclagem do carbono a gente viu que eles são muito importantes disso Nessa nessa etapa E a gente
tá falando aí do próprio dos aprofagos né só que eles que estão ali comendo a matéria orgânica hoje o que a gente vai tá dando um destaque são precisas carinhas aqui ó parte desses organismos simbiontes que são aqueles que vão tá trabalhando com a gente na parte das micorrizas e o só prófugos eles são aqueles que formam a base da ciclagem de nutrientes a gente já falou para vocês Oi Nick existem cadeias de carbono muito Grandes e ter essas cadeias de carbonos enormes Quem são os rapazes capazes de quebrá-las somos fungos sem os fungos a
gente teria um arco no ano de meninas né etc a questão do ambiente seria uma dificuldade muito grande para gente se Claro determinados compostos de carbono vamos adiante as micorrizas é o que que é que vence a me corrida muita gente confunde me corrida com fungo micorriza é um tipo de fungo não me corrida não é um fungo a Palavra na verdade ela deriva né microfungos Fiz a raízes e me corrija o nome da associação entre fungos e raízes Então me corrija Se eu estiver errado mas na verdade as micorrizas são simbioses entre fungos e
raízes ele é um processo já muito antigo é um processo de coevolução entre plantas e fungos e eu vou mostrar para vocês como é muito fácil enxergar esse processo de coevolução Entre esses organismos através do entendimento de como essa Dependência essa relação foi sendo formada ao longo do processo evolutivo das plantas e do eu acho associação do tipo mycorrhiza inclusive ela é muito ela foi muito importante para conquista do ambiente terrestre então quando o fungos e plantas começaram a se associar lá no início do processo de diversificação das plantas né aquilo ali ajudou mundo as
plantas a conquistar o ambiente terrestre e foi tão bem sucedida essa Relação entre as duas partes que até hoje a maior parte das plantas permanece associada aos fungos e a gente estima que essa relação ela começou há aproximadamente 400 milhões de anos atrás quatro e ela é uma simbiose que pode ser facultativa ou obrigatória isso a depender de quem que a gente tá olhando nessa a gente tá olhando na parte do Fungo ou se a gente tá olhando a parte da planta ou se a gente tá olhando de que tipo de Micorriza é que nós
estamos falando aqui então ao longo dessa aula você vai ficar um pouco mais claro mas é já para dar um spoiler aqui para vocês por exemplo em fungos que só vivem em Associação com algumas plantas e tem alguns grupos de plantas que são bastante Independentes de fungos outros que vivem muito bem sem elas mas se a situação apertar um fungo vem muito bem a calhar tá bom legal é um características gerais da interação Vamo falar senão forma geral depois a Gente vai dar uma detalhada nesse processo é é bem elas são as simbioses mais abundantes
da natureza né porque que são as simbioses mais abundantes da natureza porque basicamente elas ocorrem entre 80 a 90 porcento das plantas vasculares estudadas que são plantas vasculares lembra que a gente estudava lá no ensino fundamental e as plantas elas dividiram né em briófitas pteridófitas gimnospermas e angiospermas Então as Briófitas são as plantas não vasculares todas as demais já são vasculares então todas essas outras plantas todas as não briófitas a gente já tá falando das plantas vasculares e ela de 80 90 porcento dessas plantas então estudamos as percebemos que elas possuem associações do tipo micorriza
então existem associações com fungos ocorrendo nela tá e Olha só que coisa interessante né é a gente sabe que tem mais ou menos 300 mil Espécies de plantas que existem né 300 mil espécies de plantas olha muito muito espécie de escrita Então essas 300 mil espécies de plantas 80 90 porcento delas são colonizados por aproximadamente 180 espécies de fungos micorrízicos do tipo arbusculares ou seja um pequeno grupo de fungos 180 espécies são capazes de colonizar a maior parte de todos os vegetais que a gente encontra na natureza tá é um fungos micorrízicos do tipo arbuscular
existe um outro tipo bem Abundante de corrida também são micorrizo tipo ectomicorriza daqui a pouco eu vou mostrar um quadro geral esses já colonizam um grupo as plantas existem mais ou menos umas cinco mil espécies de fungos Então essas já são jamais espécie específicos a gente vai detalhar isso daqui a pouco um pouquinho mais claro para vocês mas características gerais a gente vê que são sem interações muito abundantes ocorre Praticamente em todos os lugares Eu não que já deu spoiler de 300 mil espécies vegetais eu queria que vocês gravar sem só esse número Zinho aqui
ó 300 mil espécies vegetais e sempre 180 espécies de fungos Olha só quando a gente imagina nisso né a gente já consegue imaginar que lá no início da evolução da divergência dos espécies vegetais um pequeno grupo de fungos são esses caras aqui ele se associaram com a Provavelmente o ancestral desses 300 mil espécies vegetais aqui ó O fórum foi evoluindo juntos e essa e essa Associação foi se espalhando e a diversificação dos vegetais acompanhou esse grupinho aqui de micorrizas do tipo ar muscular tá bom Como que ocorre esse processo de simbiose ocorrer mais ou menos
daquilo que a gente falou para vocês com relação as bactérias endofíticas né as plantas selecionam ativamente a comunidade de fungos partir de que forma bem a primeira partir de uma compatibilidade estrutural a gente Tá falando de dois organismos eucarióticos né então existe ali já uma relação de proximidade é em termos disso morfologia celular de estrutura de paredes celulares entre tal que já facilita muito conexão entre esses organismos a seleção E se ela vem muito em função dos resultados radiculares e dos filhos depósitos lembra que a o abordei essa questão de riso depósitos por exemplo com
as descamações é da células conforme As raízes não cresceram etc e tal então isso daqui tudo para planta possui um alto custo ajudado radicular de secretar os produtos nessa moléculas de carbono geralmente em baixo peso molecular que a planta vai produzindo alguns alimentos muito bons vale para microbiota solo é porque ali é um alimento o carbono lábio super fácil de ser assimilado mas a planta tá ali ó fotossintetizantes aquilo e tá jogando no ambiente para que que ela vai fazer aquilo quando ela Precisa geralmente de ajudo ela vai recrutando determinados organismos jogando aqui no ambiente
e quando é um fungo do tipo é micorriza arbuscular jeito você viu já pela aquele índice que eu dei de 180 fungos colonizam 300 mil plantas a gente percebe que não é muito específica essa relação né então os fungos com o único fundo ele é capaz de coloniza várias plantas diferentes várias espécies de plantas diferentes então ele vai ali ele Vai achar um fundo que tá próximo ele vai colonizar planta e ele vai auxiliar aquela planta ali no desenvolvimento dela através de mecanismos que a gente vai explorar mais adiante é a planta comanda esse processo
de seleção do microrganismo quando ela está numa situação ótima então ela vai reduzir por exemplo aceso da ação ela vai reduzir o recrutamento e ela vai reduzir a sua capacidade de ser colonizada por microorganismos E a sua capacidade de fazer a associação do tipo micorrizas tá uma coisa muscular é que tu micorriza e assim por diante e hoje a gente considera Sete Tipos diferentes de micorrizas então por exemplo tenha micorriza arbuscular em a ectomicorriza tem indo ectomicorriza micorriza arbuscular ide monodroid ericoide e orquidoides hoje aqui que diferencia cada uma dessas desses tipos de associação micorriza
né basicamente são as formas o que essas é essas Associações entre um fungo e a planta ocorre no interior da planta relação por exemplo a forma com que o fungo interage em relação a nível celular mesmo então por exemplo que que a gente tem aqui a gente tem como se fosse uma raiz da planta já está cumprida que ele tá mais bonita que a raiz eu fui lá e cortei aqui ó eu fiz um corte é transversal cortei E aí eu virei tô olhando aqui ó bem ao longo do corte transversal E aí cada um
Desse nesses dessa fatia da pizza aqui é um tipo de associação das micorrizas né então por exemplo algumas delas a gente vai explorar muito bem outras a gente só vai citar aqui porque também não faz sentido a gente querer isimill sai detalhar cada um desses tipos é importante a gente entendeu geral e depois quem tiver interesse de estudar profundamente o pai na literatura descobrir esses detalhes mas por exemplo olha que interessante né a micorriza Arbuscular ela por exemplo forma esses arbúsculos que a gente está vendo aqui por exemplo no interior das células se a gente
olhar o único que forma arbusculo mesmo essa daqui oi e ela tem outras características como por exemplo ela forma vesículas internas ela forma vesículas externas que tem um físico externa né ela não forma por exemplo um manto externo aqui da redor da da raiz com essas são características da micorriza do tipo arbuscular Mycorrhiza do tipo ectomicorriza ela já é um outro tipo de fungo que cria essa Associação e olha ela não entra dentro né das células ela cresce por entre as células tá vendo aqui ó aqui depois a gente vai explicar isso tudo que olha
ela cria uma espessa camada ao redor da raiz ou para a gente vai falar sobre isso e não tem nada de arbúsculos já a indo é que tu micorriza Ela já tem características diferentes e parece menor aqui por fora ela é entra Aqui mas também a dentro pouco o interior de algumas células a gente olha os do tipo porque doid ela forma determinadas estruturas internas dentro de as células Arbo Toy diferente a monotonia tô pôde também cada uma tem uma forma de interação a nível celular e características morfológicas em termos das associações que elas desenvolvem
aqui dentro bom então por exemplo quando a gente começa a estudar lá então aqui uma Tabelinha vai trabalhando as características Eles já tentou organizar uma sériede informações por exemplo o fungo é ele é septado ou a sepultado quando a gente olha na na sala tabela a gente vê que todos os tipos de formação de micorrizas formam-se são formados por fungos septados com a diferença do Fungo a que formam as micorrizas do tipo arbuscular que significa isso significa que quando a gente olha uma hifa fúngica ela não tem mais a divisão células Únicas Olha ele tem
um septos tá uma forma basicamente um duto multi nuclear Tá vendo como se fosse um grande duto e transportador de substâncias é Super eficiente no transporte de substâncias por exemplo do solo no interior da planta até mesmo entre plantas como alguns autores defendem a essa participação das micorrizas né aí a por exemplo uma característica e quando a gente olha outras características dessa por exemplo vamos Olhar lá eu tenho grupos por exemplo né como por exemplo a heritales O que é do tipo da do e coriza argo Toddy ele dá só nesse grupo de plantas ou
por exemplo quando a gente aí calhas aqui também ou por exemplo quando a gente pega monopólio Eles apenas nesse grupo de plantas work Dodge ele ocorre apenas em orquídeas Então são específicos de grupos de plantas tá não tem todas essas características e quanto por exemplo micorrizas do tipo arbuscular Ectomicorriza e Endo ectomicorriza ele já ocorrem tanto em gimnospermas como angiospermas são aqueles grupos mais abrangentes É verdade é disparado mundo disparado mesmo as micorrizas do tipo arbuscular são aquelas que são amplamente distribuídas tá e a gente tem aqui é só um minuto e a gente tem
aqui por exemplo as ectomicorrizas como também sendo bastante presente essas duas a gente vai detalhar um pouco melhor as Demais a gente vai entender que ocorrem que são distribuídas em grupos específicos de plantas e que tem características específicas às vezes como por exemplo uma olhar que a tabela é eventualmente por exemplo são só como as come-cotas outros são de base de uma e contas aqui no caso por exemplo da arbuscular são os digo micos retos quando a gente tá falando por exemplo se por exemplo produzem manto fúngico a gente vê que alguns produzem outros não
Produzem alguns fazem mais ou menos alguns tênis é colonização intracelular outros e extra-celular a alguns formam uma rede de hartig que a gente vai acrescentar daqui a pouco para vocês alguns formam vesículas Na verdade só um forma vesícula né arbúsculos se provocam alterações nas Raízes do que que essa alteração são alterações visíveis a olho nu né a gente vê por exemplo que quando tá colonizado por uma micorriza do tipo Muscular e você pega uma planta um capaz da gente saber se ela tá ou não colonizado por aquele fungo apenas ao olhar para ela porém eventualmente
quando tá com uma ectomicorriza a gente vai vir só de olhar na raiz se você já matou a charada falou aí que tu me corrigir aqui já cansei de ir para o campo puxar a isso mostrar para os colegas aqui ó tá vendo essa coisa aqui ó que é maior que também conheço acontecendo tá então isso é muito Interessante por essa tabelinha já dá para ver muita coisa muita informação sobre o que e esses vários tipos de associação nas Duty para me conheça e vamos adiante micorrizas arbusculares Essas são aquelas ocorrências né bem antigamente a
gente achava que elas eram exclusivas de um único gênero era um gênero gromos Hoje em dia a gente entende que não é assim a gente sabe que elas são exclusivas da ordem glomales Porém o presente sim 18 gêneros né a gente entende que ela é tão presente por exemplo em 11 famílias mas ainda assim é um grupo bem restrito que se a gente pensar na quantidade de plantas que elas colonizam eles tem distribuição Mundial como eu já falei para vocês ocorrem na maior parte dos vegetais vasculares eu sou muito mais abundantes que as ectomicorrizas es
e olha só essa informação que coisa interessante né o mistério extrarradicular ou seja fora da Raiz pode atingir de 14 a 50 metros em um grama de solo Ou seja a quantidade de micélio terminando um grama de solo pode ser tão grande que se você fosse capaz de esticar isso linearmente poderia chegar a 50 metros por que absurdo né Então vamos pensar em Agora Numa microescala na escala ali no nível de fungo nível de raide de bactérias nível de solo e nos microambientes por exemplo de um agregado de solo imagina a capacidade de exploração dos
recursos Que a gente tem quando a gente tem esse nível por exemplo é a superfície de contato no solo é absurdamente maior do que por exemplo quando a gente compara com a capacidade que a raiz pura tem um contato conosco lembrando o que que quando a gente está falando de capacidade de obtenção de recursos de uma raiz a raiz absorve aquilo que vem curti fusão fusão normal junto com a água mais nada então tem que estar perto ali na superfície de contato Que que é uma coisa interessante das micorrizas arbusculares e a gente nunca até
hoje foi capaz de colocar uma micorriza arbuscular dessa 180 espécies que tem apesar de elas estarem em 80 90 porcento das plantas você já Apesar dela estar em todos os lugares a gente nunca conseguiu colocá-las numa plaquinha de Petri pura e cultivar e deixar na Bel de ali para crescer linda e maravilhosa nunca conseguimos somos incapazes até hoje Fazer isso porque porque ela perdeu a capacidade saprofítica dela Olha lembra que eu falei para vocês que vai demonstrar claramente como isso era um processo de coevolução mais uma coisa para provar que não só a gente tem
o pequeno grupo de fungos né uma única ordem de fungos colonizou todo o reino planta deles e como é se esse grupo de fungos aqui ó não vive longe das plantas ela é que ela é incapaz de viver por si só perdeu a Capacidade saprofítica lá não tem a capacidade por exemplo chegar no meio ambiente e sair quebrando por exemplo as cadeias de carbono e viver por si só esses organismos né eles são produtores de esporos esporos dele estão espalhados por aí então esses poros eles são capazes de germinar mas após germinar e não encontrar
uma planta que morre né e não só a planta é necessária para nutrição esse organismo como ele é a planta responsável pela regulação gênica É um esse grupo de plantas que tá aqui ó e é capaz por regular os genes deste grupo de fungos que tá aqui tamanho dependência que um desenvolveu do outro tá então quando a gente fala que ele não é cultivado em condições aqui cênicas é livres de outros organismos tá bom não conseguimos fazer isso então a gente até consegue por exemplo junto com uma cultura de tecidos manter um fungo vivendo numa
placa de Petri mais livre completamente livre não conseguimos e Olha só que empecilho que isso é hoje o desenvolvimento de produtos à base de fungos micorrízicos e fazem associação do tipo de coisa músculos eu vou mostrar umas imagens muito lindas para vocês mas daqui é uma micrografia né a gente tem aqui um corte longitudinal de um tecido então a gente vê dentro desses tecidos a formação de vesículas Olha que coisa linda vesículas internas qual é a função dessas vesículas armazenamento de nutrientes Então reservas por exemplo de carbonos de pedidos e tal para nutrição do fungo
e da planta e aqui hifas saem da Raiz e vão para fora dela parece bom então a gente tem nesse caso né aqui um desenho só para vocês entender ele esses tijolinhos aqui internas são as células vegetais a gente tem um pelo radicular que eu indico Lar é uma parte da célula da planta que sai e é onde faz absorção de muitos nutrientes tá então aqui ó que acontece aqui no primo Radicular olha aqui no pelo radicular esse fundo Entrou tão que tem uma compatibilidade estrutural fundo entrou aquele sai da parte externa para interna ele
vem aquele criou alguns novelos tá vendo ele não vê-lo e aquele forma arbúsculos Esses arbúsculos são como se fossem alvéolos do nosso pulmão esses arbúsculos eles são as regiões de troca de nutrientes do fungo para dentro da planta tá esses arbúsculos eles não tem uma longa vida ele Já faz um tempinho e depois eles vão se desfazer vai ser digerido ali dentro da célula vai virar nutriente ou fungo vai criar um novo ao busco me mostra célula e aquilo ali vai ser como se fosse uma zona com alta superfície de contato para trocar as vesículas
elas ocorrem de forma interno e elas correm e forma externa então tem vesícula dentro e fora da planta e existem grandes bolsões de esporos né que serve como propagação do Fungo quando aquilo nesse fundo aí é Estourar quando esses homens Se romper alguma coisa assim esse solo vai ser espalhado ou alguma coisa do tipo ele vai conseguir colonizar outras raízes por ali Ok funciona mais ou menos desta forma Oi aqui é uma micrografia mostrando uma célula vegetal é uma célula vegetal né E aqui um arbusculo muito lindinho no outra micrografia mostrando então aqui a a
hifa do fungo e o ar busco olha aqui como que ele chega a ser muito fino com Essa aqui é a são as trocas nem parece bastante no alvéolo pulmonar onde ele vai fazer as trocas de nutrientes a especializados com as plantas ó e aqui alguns mistérios e bolsas de esporos então que a gente tem umas bolsas de esporos é que os esporos de fato A Iá identificação desses fungos ela ainda é feita é pelos especialistas pela morfologia dos esporos né então alguns esporos eles são bem grandes a gente Consegue ver a pena por uma
única lupa e ela forma por exemplo que gênero Bruno's e os poros da cama espora pela morfologia dos esporos velho pelos moções etc e tal especialistas no assunto eles conseguem saber qual é o gênero eventualmente até mesmo a espécie de micorriza que está ocorrendo no ambiente feito agora vamos falar no segundo tipo me corrija mas abundante que são as ectomicorrizas né as ectomicorrizas elas Já não são tão específicas elas não são de uma única ordem ela já pertencem a mais de um filo então elas por exemplo pertence ao vivo basidiomiceto ascomicetos e zigomicetos elas são
bastante predominantes principalmente em florestas de coníferas ou Pinheiros né de regiões temperadas Mas elas também ocorre amplamente aqui nos trópicos existem aproximadamente de 5 a 6 mil espécies muitas espécies estão associadas a aproximadamente 10 por Cento das angiospermas tá Então olha a diferença a gente falava antes de 180 espécies colonizando a 90 80 porcento dos vegetais vasculares e aqui gente está falando de 5 a 6 mil colonizando 10 por cento então aqui ver um processo que contra ocorreu bem mais tardiamente no processo evolutivo e aqui a gente tem uma seleção espécie-específico muito mais forte né
aqui por exemplo a espécie vegetal ela não coloniza qualquer ectomicorriza e Vice-versa aqui o tipo de que tu me corrige a sua da em alguns tipos de vegetais e e assim acontece não é não é aquela promiscuidade que a gente tem na micorrizas arbusculares tá é como eu falei antes elas promovem alterações estruturais nas raízes e aqui tem uma coisa muito legal Tomás estruturas bonitas que que acontece quando é que tu vai no fundo vai crescendo ao redor da raiz ele vai criando que a gente chama né Desse muito Fúngico eu isso aqui é um
acúmulo dos mistérios Tá vendo chama no Manto fugir com isso daqui Oi e aí o que acontece esses caras eles não crescem dentro das células mas eles também trocam nutrientes eles trocam nutrientes pelas laterais tá vendo pelas laterais fica saíres Oi e essa estrutura que eles crescem aqui pelas laterais são chamadas redes the heart is a rare Kinect rede Hart isso são as características específicas Dos fungos micorrízicos dos fungos das associações do tipo ectomicorriza tá dos fungos ectomicorrízicos Ah e por quê que eles criam deformações nas raízes olha só ele vai crescendo por aqui ó
e esse mando fúngico vai como se fosse estrangulando porque a raiz cresce nessa região aqui ó conhecida como coifa então ele Peço pela ponta conforme vai criando essa rede e manto fujiko ele vai virando um cotoco e vai strango Lando esse crescimento Mas isso não é um Prejuízo porque essa e faz elas vão fazendo outro prolongamento na Raíssa e aqui tão ilustração mais bonitinha né do manto fúngico e entre as células a rede Heart on o técnico e aqui alguns micrografia para a gente entender bom e muito interessante por exemplo aqui a gente tem a
demonstração do que ocorre com um basidiomiceto que muitas vezes quando a gente anda pelas Florestas e a gente vê um cogumelo a gente acha que esse cogumelo aqui tá simplesmente do Contorno mamadeira mas eventualmente não eventualmente ele é o corpo de frutificação por exemplo de uma ectomicorriza muitas ectomicorrizas formam esses cogumelos podem fazer chapeuzinho outros vou mostrar daqui a pouco e na verdade eles estão aqui ó saindo do córtex da Raiz e os mistérios vão acabar lá em cima ele se propagam pelo ar na verdade ao invés de apenas Sendo os as bolsas de esporos
internos como é o caso das micorrizas arbusculares conforme por exemplo esses cogumelos pelo chão o dinheiro sem ser bem comum mas existem muitos outros a existem esses daqui que são chamados por exemplo de coffee House São depois eles botam no YouTube poste Ball é cogumelo alguma coisa assim para vocês verem que isso daqui uma bolsa de esporos eu vou mostrar aqui no final da aula depois por vocês esses pontos bons Esse aqui precisamos pisolitos aqui tem um outros tipos né esses caras eles são todos micorrizas do tipo é que tu micorriza eles são uma bola
de descobre e esse alguém pisa nele um animal alguma coisa alguma coisa Cai ele ele joga uma bola de Manu vem de esporte para cima por isso que é normal em inglês que chama incrível quantidade de esportes que eles são a moto aqui é uma foto fotografia da raiz mesmo com esse aspecto enovelado tá Vendo e essas coisas que parece uma teia de aranha na verdade nada mais é do que os micélios formados esses mistérios aqui ó você é muito fácil de ver quando você começa a escavar uma raiz no solo muito fácil aparece que
uma teia de aranha foi feita Mas eu só tenho de aranha nada mais é do que os mistérios das plantas né Elas Ficam todos esses cotoquinho assim é mais difícil ver o que eu tô aqui mas as três dias é muito fácil E olha só a expansão que essa a esteve no Incrível as diferenças entre os dois tipos bem fácil de ver Oi e o último tipo que eu queria mostrar para vocês que eu acho lindo né são as micorrizas orquidoides e o que que eu acho interessante da ok doid Aqui aqui a dependência muito
grande é da própria planta em relação ao fungo né é uma relação de simbiose mais dependente do que as outras que a gente tá falando Porque por exemplo no caso das ectomicorrizas tanto fungos contra o plantas vivem bem separadamente mas numa situação de stress eles vivem melhor juntos no caso das micorrizas arbusculares as plantas vivem bem sem assim assim os fungos os fungos precisam da planta mas no caso dos micorrizas orquidoides né a essa essa simbiose ela é muito dependente das duas as duas precisam muito delas olha as orquídeas elas são a maior família de
Monocotiledôneas do mundo né Elas têm entre 17 e 30 min e esses e elas precisam desta relação do tipo micorriza para a propagação e manutenção que que ocorre né Deixa eu ver se eu tenho mais um tem umas três então a gente vê a esse tipo de de relação assim não nas raízes das Orquídeas isso aqui são escamas né da própria da própria raiz a gente tem que entender que associadas a Essa saíres tem também uma quantidade enorme de Fungos eles colonizam o interior dessas raízes e formam essas esses enovelados que se chamam teletons esses
pele tons né então enovelados de hifas que trocam eles transformam um redes de trocas é é de nutrientes Assim como as outras mas não é só isso que interessa em fazer as por exemplo a orquídea ela tem uma semente muito pequena então quando ela começa a germinar nos primeiros momentos da vida da Orquídea Quem é responsável por nutrir a planta são os fungos Então Os fungos eles são transmitidos verticalmente ou seja da planta-mãe para plantar filho e essa essa colonização nos primeiros momentos da vida é primordial para que haja propagação da Orquídea EA manutenção da
vida dela na natureza é um processo de coevolução também muito claro onde a gente precisa das duas partes para que possam viver e permanecer vivos ao longo do tempo E para finalizar essa parte das associações aqui Dizer para vocês que Especialmente no caso das micorrizas arbusculares em a gente tá aqui falando de alguns claro que os fungos eles têm mecanismos de transporte específicos para buscar no solo por exemplo diferentes fontes de nitrogênio então por exemplo amônio Nitrato aminoácidos em ureia por transportadores específicos para pegar e isso e levar para a planta por exemplo apenas já
nitrogênio na forma de amônio ele também tem por exemplo é transportadores para absorver O fósforo inorgânico na forma muito utilizada transportar isso na forma de polifosfatos ao longo das redes de hifas e transpor e transportar isso na forma de fósforos inorgânicos né o números a planta também por transportadora os riscos e que recebe também por meio de transportadores específicos pequenas moléculas como por exemplo octose sacaroses e outras coisas por meio da planta ou ele tem todo uma rede já de morfológico o molecular vão dizer de Interação para que tudo isso seja mais utilizado E aí
e os benefícios dessa Associação né o fumo são muito olhos vistos nos recebe energia eles recebem proteção porque dentro da planta eles estão mais protegidos do que no solo onde é o mundo cão né eles percebem também que no processo da regulação gênica que a gente já conversou que as plantas modulam para eles Olá aqui é o mesmo vai ver Deu uma deixei bonito todo cheio para a planta a gente tem o benefício direto para planta ele ele começa por uma coisa gente ampliação da superfície radicular o principal benefício da planta isso a gente pega
uma raiz que tem uma superfície de radicular x e faz essa superfície virar 10x e quando essa superfície virar 10x o que que acontece a gente aumenta muito a sua localização de compostos como fósforo potássio Aquisição de Ferro absorção de água qualquer coisa que precisa tá a gente otimiza a fixação de nitrogênio olha só o que eu tô falando o otimiza a fixação de nitrogênio por quê É porque quando a gente dá maior disponibilidade de nutrientes para a planta outras simbioses vão ter maior disponibilidade de nutrientes para fazer o seu papel os fungo não fixam
nitrogênio porque nenhum eucarioto fixam nitrogênio Tá bom mas ele ele consegue Otimizar a fixação de nitrogênio outros organismos Ok não coloquem que o fungo vai ficar nitrogênio por favor e ela aumenta por exemplo a tolerância ao estresse hídrico protege a planta do estresse hídrico não só porque ele aumenta a capacidade a capacidade de captação de água como por exemplo e proteja aumenta por exemplo a produção de exopolissacarídeos ele mantém a cobertura da raiz ele tem uma série de formas ali que melhores se processo Aviso continue continue a e ele consegue reduzir uma série de atenuação
de danos ele consegue por exemplo é a tendo o melhorar por ser resistência metais pesados essa essa questão que eu vou falar agora ela é um pouco controversa né Tem autores que reforça o riso tem autores que diz que isso não acontece tá a translocação de nutrientes entre indivíduos diferentes que que isso quer dizer o seguinte em uma floresta né Tem Autores que falam que uma planta é mais saudável por exemplo doa nutrientes para uma planta menos saudável dentro dessa floresta e tá uma translocação de fotossintatos e outros processos nitrogênio você crê tal de uma
planta para outra e esse processo se dá por meio de uma rede de fungos do tipo usar muscular não é que tu me corrige a etc Então é isso é controverso o que é conhecido já assim relativamente provado é que a sinalização química entre Plantas então por exemplo dentro de uma floresta levam pensar aqui se vem me chame de um determinado dê certo E aí começa um processo de herbivoria na borda essas plantas Elas começam a ser atacados Elas começam a produzir um determinado sinal químico esse sinal químico sim é transportado numa rede é do
tipo ectomicorriza uma coisa muscular chega em plantas por exemplo no centro das Comunidades de vegetais entendem o que está acontecendo e passam por Exemplo é produzir compostos secundários que aumenta o defesa contra herbivoria quando esses insetos Chega no centro ele já não vão ali se alimentar dessas plantas porque o aumento nesse de compostos secundários promove defesa contra esses insetos Ok então isso acontece e também é por exemplo a gente tá falando aqui do produção o acúmulo de fitormônios né que são as substâncias reguladoras de crescimento a floração é E alterações bioquímicas relacionadas à produção de
compostos secundários não tem muitos benefícios aqui relacionados ao processo da planta que tem um pequeno vídeozinho Deixa eu ver se eu vou conseguir há quanto tempo não é e coloca para você eu mostro aqui na verdade um produto mas ele mostra a mesma sozinha mostrando a colonização porque tem um esporro por exemplo por germina ele já coloniza a planta forma Os arbúsculos as vesículas ele mostra toda a característica de capacidade de captação de fósforo e nitrogênio água potássio e melhoria no desenvolvimento vegetal e ali como ele amplia a área de absorção tá mais ou menos
assim que funciona o processo de colonização de um fungo do micorrízico é interessante que depois de uma colheita é esse solo ele vai ficar cheio de esporos né é uma ele pode ficar permanecendo com maior capacidade para Os próximos cultivos e isso é muito interessante que a gente pode ver que solos às vezes muito agradados eles podem ser adicionados de o solo e tem um alto nível de colonização com micorrizas para que ele tenha presença de novos os poros possa se colonizar e aquilo ali seja por exemplo mecanismo e Recuperação aquela área que tá degrada
o fatores de influência nessa colonização disponibilidade de nutrientes de que forma volta É de que forma que isso funciona funciona assim quanto mais nutrientes eu tenho a tendência é que eu tenha menor colonização do tipo micorriza por quê porque a tendência Nossa é que a gente Peça ajuda quando a gente precisa de ajuda se é caro para planta manter essas associações ela vai usar ela vai lançar mão desse recurso quando ela precisa de ajuda tá se o solo foi muito Desculpe foi muito nutritivo muito OK a planta não vai precisar isso tá em relação ao
PH a tendência é que p a gás bolos é vão ter melhor presença de fungos por quê que pega a bola e vamos colocar mais próximo da neutralidade da gaze extremos tendem a eliminar atividades biológicas Então a gente vai ter menor atividade física a presença de elemento tóxico pra fungo como por exemplo a aplicação de eet fúngico vai reduzir obviamente a presença é das desse tipo de associação a mesma coisa a salinidade né agora em Relação a textura estrutura agregação densidade a gente tende a presença né da fungos e tende a melhorar todos esses fatores
os fungos eles ajudam muito na estruturação do solo eles ajudam muito a melhorar o processo de agregação quando a gente melhor agregação a gente melhor estrutura a gente melhora a densidade que a gente diminui a densidade diminuindo a densidade a gente deixa apelos formais a e lado a gente deixa melhor para o coração da água num Processo mais saudável né é mantém melhor Boa tarde e geralmente é a questão de organismos isso é muito variável né a gente sabe que o organismo Ele interfere em outros então a presença de outro organismo sempre a normalmente organismo
a uma coisa que a gente não dá para falar assim organismo x ou Y isso vai ajudar ou diminuir por exemplo processo é o ter ou não dinheiro uma associação do tipo de coisa mas a gente sabe que a Biologia em influencia na própria biologia a gente lista que organismos influenciam mas não é um processo aqui controlável né e são todos os fatores do soro quebrou acabar influenciado ou sendo influenciados pela presença do fungos e ajudando ou sendo ajudados nesse tipo de associação o apelante a gente sabe é que o que influencia né não ocorrência
desse do tipo e na ocorrência desse processo de Micorrizas é a espécie ou a variedade até dependendo que a gente tá falando vegetal a a algumas plantas elas vão selecionar determinados fungos outras ou selecionar outros também a nutrição dela pelos fatores já explicados a idade da planta a gente tende a alterar eventualmente o grau de micorrização dela com o tempo ela tende a ter uma maior micorrização na fase de crescimento dela é se ela tem atividade alelopática ou não algumas Espécies estendem até Maior alelopatia Que As ajuda a São por exemplo de compostos inibitórios por
exemplo de outras espécies que se ela tem maior ou menor atividade de exudação isso é importante o manejo influencia e claro que oferecia né então por exemplo Qual é o histórico da área acabei de falar para vocês que os fungos eles não vão embora de uma mande para o outro tem um esporos ali é um dos esportes eles permanecem O que é um cultivo nem logo no cultivo o Seguinte você também bota uma espécie que pode ser colonizada pelos recorridos que estavam ali né todos os tipos de fungos que forma associação do tipo micorriza ótima
aquilo ali vai prevalecer e vai ser mantido a um histórico da área e influencia o tipo de cultivo também então por exemplo eu faço um cultivo direto plantio direto Ah não eu não faço o crédito direto aí é um boto vou botar milho milho vai vai acontecer uma coisa vou botar cana vai Acontecer outra passa o trator trator por exemplo gradagem é uma coisa muito ruim porque ele vai quebrando as redes de hifas como é que formam dos fungos isso daí atrapalha por exemplo uso de insumos você vai aplicar de fugir como farsa vai acabar
com as suas seus fungos que estão ali se você é muito ruim o que você precisa está com a doença às vezes é necessário né agora ficar aplicando sabe é já antes de ocorrer alguma coisa eventualmente você tá dando Um tiro no pé as duas coisas a gente tem que pensar tudo isso influencia também tá dando para fertilizante demais você vai inibir por exemplo a presença de micorriza lá e agora eu queria que você desse uma pausa a dar respirado quase com uma horinha de aula aí que agora eu vou mostrar uns estudos de casos
bem rápidos que é para gente poder finalizar com o entendimento prático desses conceitos ok e descansar chuchu E olha só aqui tem uma tabelinha que eu peguei uma revista biotecnologia ciência e desenvolvimento onde eles são mostra aqui algumas culturas variadas muita gente tem que abacaxi citros milho plantas árvores e quais são os fungos que são eficientes na colonização a gente em vários glomus vamos Claro luz é aquele katon a gente tem aqui por exemplo a cala os por a gente tem algumas coisas aqui são todos no micorrizos do tipo arbuscular e qual É o efeito
da inoculação desses organismos então a gente pode ver aqui por exemplo melhor desenvolvimento de mudas é melhor tolerância ao déficit hídrico a gente pode ver por exemplo melhor nutrição crescimento estimulado isso aqui é muito interessante ó maior eficiência do uso de fósforo e isso é uma das coisas mais relatados são a utilização de micorrizas tá é essencial para o desenvolvimento de mudas de espécies pequenas semente pequena porque Espécies de semente pequena significa que ela tem pouca reserva ela a reserva ela precisa rapidamente se adaptar e aprender se nutre sozinha tá então é muito bom quando
ela pode ajudar com fungo para ajudar ela nesse crescimento inicial Tá bom Aqui tem alguns exemplos né que a gente pode observar e eu trouxe também algumas fotos de experimentos que a gente fica direito algumas apresentações coisas para gente ir ver como é que funciona Olha só que tem aqui que a gente tem a gente tem milho e sódio tá bom em cima a gente tem milho e machos têm sódio e a gente tem ambos controle que controle não botaram nada no negócio botar um vaso deixar o crescer e a gente tem fósforo rec que
fósforo aqui é a dose de fósforo recomendada sem fungo micorrízico arbuscular eles ficam pequenininho tá vendo aí eles botaram por exemplo diferentes concentrações de fósforo que seria um terço do fósforo Recomendado e um terço do fósforo recomendado até a dose completa do do do fósforo recomendado Então esse daqui é igual a esse aqui ó e esse aqui é igual a esse aqui qual é a diferença dos dois e se tem fungo e se não tem fogo a diferença dois obtiveram tiveram a mesma quantidade de fósforo a diferença de um com o outro que um recebeu
fungo ou tu não recebeu o frango e que a gente entende aqui o fundo ajudou absorveu fósforo que é que ele Precisava que ele tinha disponível ali no ambiente agora olha que interessante esse cara que recebeu um terço do fósforo recomendado Mas recebeu o fundo também quando o desenvolvimento dele é igual do lado o ou seja se você aplicar um terço do fósforo mas aplicar o fungo você tem um crescimento muito superior aplicar o fósforo inteiro mas não aplicar o fogo a mesma coisa aconteceu para soja tá então a gente vê que a importância dos
fungos Na momento da superfície radicular e não é suficiente de absorção do nutriente o e daqui é diferente essa que já é diferente nices ele tinha uma uma espécie de citros que uma laranja caipira ele colocou o controle coitado Esse controle aqui né não é possível vou falar uma coisa para você né Eu nunca gosto muito dessas faz onde a pessoa sempre apresenta uma foto mas vamos uma faca que representa o experimento mas o controle tá aqui ó só tem duas folhas Esse controle aqui coitado do controle e além desse controle aqui a gente tem
três tipos de fungos diferentes e nesse caso está selecionando qual fungo micorrízico arbuscular é melhor ele mostrou aqui que alguns meu currículo escolar que esse daqui é um cromos eu colocar tu não tinha praticamente nenhum efeito agora por exemplo esse daqui ó já tem um efeito de desenvolvimento muito grande mostrando também que não há qualquer fungo Micorrízico a depender do Vegetal cada vegetal vai se adaptar melhor ao mal espécie ou às vezes uma linhagem de fungo micorrízico tá essa Associação me critica e não vai ser essa específico e e aqui também interessante que acontece aqui
ele testa fósforo solúvel o e fósforo de rocha fosfática que o Rocha fosfática é basicamente a rocha moída tá E eles ir no culto e no cu e ele tenha dose de fóssil é zero ou seja o mercado nada né difícil 50 e 100 tá Quê que acontece aqui ó um fósforo solúvel inoculado tem esse esse e esse aqui zero olha inoculado zero cresceu solúvel não inoculado não cresceu nada posso faca fosfato que inocula do conheceu não inoculado não cresceu nada disso que a gente está vendo aqui gente quê que é isso bem séria para
cozer de fósforo isso aqui é o crescimento que só o próprio fungo que morreu ou seja já havia no próprio substrato usado aqui no próprio Experimento uma quantidade de fósforo que poderia ser absorvida Mas eu posso porque está indisponível lembra que nós já falou que eu fosse que fica disponível quando o fungo foi no lado ele foi capaz de fazer com que esse fósforo aqui tornasse disponível e aqui é o limão cravo conseguiu dizer e desenvolveu alguma coisa aqui não importa o onde foi um fungo ele não desenvolveu nada praticamente porque não tinha nem fósforo
para ele disponível aí Ele colocou uma quantidade de fósforo é que pode ser de rocha solúvel ou insolúvel ou não solúvel é uma que a gente tem as mesmas coisas mas o que acontece quando ele colocou 50 50 mg por quilograma não inoculado esse daqui ó e esse daqui Qual a diferença dos dois aqui esse não é solúvel que esse aqui é rocha de rocha fosfática e esse daqui é solúvel se é solúvel tá pronto para plantar de sorvete olha planta absorver O cresceu não Rocha fosfática planta não cresce porque vai ficar ali insolúvel a
planta não consegue pegar Quando aplica essa daqui mais o fungo o fungo solubilizar para planta bom né E Quando aplica solúvel mais fungo ele cresce melhor porque que não só dá o que a planta o que o que tá solúvel Como o próprio fungo ainda disponibiliza um esse tempo para ela e se você deu uma quantidade muito grande de fósforo solúvel que que Acontece olha vamos aqui ver o que que aconteceu um negócio e é inoculado no inoculado Rocha fosfática ou Rocha fosfática né bem aqui a gente tinha os dois solúveis né bem se era
tudo solúvel EA quantidade era muito grande de fósforo já não fez mais diferença se tinha fumo no fungo porque aí já tinha tanto fósforo solúvel e para planta já não fazia diferença mais o fogo né aqui era já A Rocha fosfática Não Adianta dar um monte de fósforo se Ficar na forma não solúvel a planta não vai absorver e aqui é o limite que pelo jeito foi capaz de solubilizar no tempo do experimento Então isso é o que a gente consegue entender aqui no experimento olha dar o A Rocha fosfática sem fungo para se organizar
planta não vai conseguir então os microrganismos são as peças com o processo de disponibilização do fósforo para a planta se vê em uma forma solúvel pode mandar mas olha para você Ter um desenvolvimento alto Você vai precisar botar uma quantidade muito grande que fósforo solúvel se fosse aplicar fungo você pode aplicar o quantidade muito menor e já vai ser o suficiente aqui é outra coisa importante O que que a gente tá vendo nesse gráfico semanas após o plantio e a gente tá vendo colonização intra-articular Ou seja que o seguinte quanto mais alto neste eixo aqui
mas a gente teve colonização tá então a gente tá falando Sobre duas espécies diferentes e a gente vê duas espécies diferentes uma espécie consegue colonizar bem que essa glomus clarão a outra espécie não coloniza uma primeira informação que a gente tira aqui a colonização depende da espécie só a gente já fala a outra colonização outra coisa que a gente falou é que a colonização depende do status nutricional Olha aqui que acontece quando a gente tem baixo fósforo e após dez semanas oitenta por cento das Plantas estão colonizadas quando a gente tem muito fóssil após dez
semanas ela Vinte por cento das plantas estão colonizadas trinta por cento na 25 porcento ou seja planta busca a colonização quando ela precisa tá então isso aqui tá muito corroborando com os conhecimentos que a gente já teve o e sobre um processo que eu gosto de falar que a simbiose tripa então é importante a gente dizer que além de tudo aquilo que a gente falou sobre Micorriza arbuscular mycorrhiza do tipo ectomicorriza a gente ainda tem as bactérias acontecendo junto então isso tudo ainda acontece no meio da bagunça inclusive as bactérias elas colônias os postos fungos
tudo acontecendo junto fungo é bactéria dentro da planta tem bactéria no fungo uma uma bagunça né e é que a gente tá mostrando é a Adversidade de ectomicorriza ela melhora o crescimento EA fixação de nitrogênio de mudas de Acácia mangium Acácia mangium uma uma planta leguminosa muito legal de trabalhei com a no doutorado no mostrar daqui a pouco para vocês e olha que interessante que a gente tinha aqui ó número de mico ectomicorrizas isolados não colados tô conforme a gente aumentando a gente vai vendo aqui Pelas curvas né maioria elas tendem a atingir um platô
Zinho aqui por volta de quatro cinco mas a gente tende a ter uma maior biomassa é Oi Diego e seu marido isso daí ó A biomassa de raiz a gente tem maior número de módulos por planta a gente tende a ter uma maior número de teor de fósforo o maior número de teor de nitrogênio uma maior teor de biomassa completa a gente tende a ter uma planta mais no trida isso conforme a gente aumenta a quantidade de ectomicorrizas diferentes que eles o inocularam então a gente vê que diversidade também está associada a um processo de
indireto de maior fixação biológica de nitrogênio Conforme eu tinha mostrado para vocês há pouco tempo atrás ó bom então aqui a gente mostra por exemplo é uma planta semi coriza e como micorriza com zero porcento de fósforo sem micorrizas ela acabou aqui ó cômico riso ela vim para cá a planta cômico riso supera o crescimento da planta sem micorriza na ausência de adubação fosfatada E aí a gente vai vendo aqui por exemplo a diferenças né do desenvolvimento delas Aqui uma come coisa que se deu 10 PPM de fósforo a outra recebeu 30 Elas têm desenvolvimento
maior é o melhor qual e aqui é o número de nódulos a nódulos formam os nódulos de fixação biológica de nitrogênio com uma e coriza e sem micorrizas em diferentes concentrações de fósforo e a gente vê Então como que indiretamente a gente Altera a fixação biológica Travessa da presença das nossas micorrizas a toxidez de metais pesados Olha o tal Desenvolvimento dessa soja aqui ó e olha essa daqui come coisa e sempre correndo em Ah e por fim a última coisa que eu quero mostrar hoje aqui um pedacinho da Minha tese de doutorado Eu trabalho com
eucalipto há muitos anos né E esse daqui é um trechinho do trabalho quer que eu fiz doutorado a gente trabalhava com o Calypso não sabe que é uma planta muito importante nem toda cenário Nacional mas não sabe que no modelo de plantio que a Gente tem também não é muito bacana processo de monocultivo acertar o que dá para melhorar e aí a gente é uma das alternativas era o plantio com a caça é um anjo que é uma leguminosa gente tá vendo aqui as raízes delas Nossa docinhos com as bactérias fixadoras de nitrogênio Oi e
a gente é trabalhava no sistema com área degradada um desenho que tinha duas áreas Na verdade era uma área sob a gente tinha blocos nessa área onde a Gente tinha só só eucalipto com fertilização sua caça de não tinha fertilização nitrogenada e a gente tinha áreas com plantio misto antimíssil a gente tinha tirado metade das plantas de Eucaliptus e tinha substituído metade por acaso e aí a gente tinha que as visão do Google Maps 11 anos do plantio o cada quadradinho aqui ó era uma composição aqui por exemplo pessoal Calypso aqui alcalipto para Card aqui
na sua casa fazer aí aqui na sua Eucalipto Por exemplo aqui na sua casa assim tá mais de dois hectares essa aqui é a vista do experimento do mercadinho aqui a gente ver as folhas de eucaliptos né aqui da caixa de dividir os lugares E olha que legal eu já que eu tô mostrando para vocês é só a partir de fungos a gente fez muita coisa que é só a partir de fungos ó tá tudo em tom de verde quando eu passo aí para esse tema aqui mas o que que a gente vê né Eucaliptos
misto e a Cássia olha no Eucaliptus e o bispo fica aqui é o carinho eucalipto gente tinha presença de base de uma cota e um pouquinho de assumir cota já na área de Acácia a gente tinha um pouquinho de base de ricota e muito de ascomycota e no Mixto Metade dos dois e quando a gente olhava isso na marra perder Nossa multidimensional na métrica des aqui área de eucalipto só assim vermelho daquelas Acácio o que a gente via cada um num canto isso Aqui era baseada na comunidade de fungos Tá mas o que significa que
a comunidade de eucaliptos ela se organiza aqui a gente interpreta esses pontos é só quem tá conectado próximo é parecido tentar longe é diferente como todo mundo aqui tá nesse canto eles são parecidos significa que os fungos daqui são parecidos e quem tá pra cá diferente e parecida entre si Então os fungos daqui são parecidos entre si são Acácio e o que tá aqui no meio é um misto esse aqui É o mix secarem aqui no meio e a gente entende o que quando a gente fazia os planos o plantio o Eucalipto tinha um fungos
os fungos do kaliptos a cacetinhos fundos da caixa e o plantio misto ele integrava os dois plantios né Oi e aí quando a gente olhava os grupos olha só o que a gente ia né a gente vê que o Eucalipto ele tinha um cara aqui ele mais da metade dele era esse cara aqui ó esse cara era esse caneta desunidos e a Cássia maior parte dos Cara dela esse daqui eles ficarem aqui não cultivadas telefonat seguida por outros grupos ali e o mestre tinha um pouco de si e de um pouco desse e depois ele
tinha um pouco desse e ele foi agrupando um pouquinho de cada um E quando eu comecei a olhar o grupo de como é zero eu falei olha entre os 25 primeiros principais fungos 17 São alterados uma parte significativamente maior meucalipto outra parte significativamente maior na Cássia e Quando eu fui olhar esses grupos aqui ó tem que eles eram era um grupo de recto mycorrhizas eram grupos de fungos que fazem Associação associação do tipo é que tá aí eu falei Poxa então é assim que é por isso que tem tanta diferença apesar de ser a mesma
área todo mundo plantado um com o outro ou Calypso selecionar a fundo o que me quer e a Cássia seleciona a que ele quer e assim a gente publicou um artigo legal mostrando como que a Chave da seleção das Comunidades de fungos no ambiente ele pode se dar pela seleção do tipo de planta que a gente quer colocar no lugar bom e isso é traz uma série de oportunidades de tecnológicas então eu acho assim todo esse conceito da aula de hoje que eu passei para vocês ele serve para entender a exploração do tecnológica nos fungos
micorrízicos é ele é uma coisa muito boa para ser feito e ele é uma coisa muito pouco Feita tá a Gente não tem empresas assim nível nacional e internacional ainda trabalhando muito com isso a gente já teve tentativas a maioria das coisas não vai muito para frente porque ainda tem muitos desafios maior desafio deles no meu ponto de vista é o seguinte o principal grupo de fungos que a gente tem para trabalhar aos fungos alguns micorrízicos arbusculares porque é um fungo ele serve para muitas culturas diferentes porém a gente nunca conseguiu Cultivar no laboratório e
fungo micorrízico arbuscular e não para produzir no cru a gente tem por exemplo que cultivar uma área para produzir esporos naquela área e vazar que ele saco com esporo e trabalhar no controle de qualidade e vender uns um solo com o esporo isso é complexo na imagina sua tudo processo disso não difícil mas é uma área extremamente importante e que eu vejo com muito bons olhos eu já falei isso né meu grupo ele Carece de pessoas para trabalharem com fungos eu vejo que essa área uma área de muita importância o exemplo né que esses dados
quando a gente viu isso e eu trabalhando pocalipse sabendo que naquela área lá era a gente tinha importância do pisolitos e que ele era um cara tanto a gente foi lá para praia né eu pisolitos é esse carinha aqui olha eu não sou profissional da vida e eu já fui com meus alunos lá para área de trabalho E depois ir catucando só a gente já achou ele hoje foi esse carinho aqui ó esse episódios você corta ele é bonitinho assim então a gente vai lá no meio do mato a gente acha ele legal que você
coleta amostra do solo manda sequenciada um resultado você volta para o campo se olha lá e tá lá o bicho sabe Mas recentemente fui lá para Bahia e a com aluno a gente viu isso daqui ó olha olha que é que tu micorriza vocês querem ver aí acaba aqui no chão aí você vê Direitinho a raiz do eucalyptus saindo de lá tá aqui o fungo com o corpo de frutificação que a gente já está tentando isolar no laboratório Tá difícil mas espero que vocês tenham entendido todo o potencial e todas as coisas interessantes que tem
para sair daqui e gostado dessa aula é um tema que eu gosto demais eu acho muito lindo de ver como que se um fungo o como que os fungos e as plantas decidiram viver e é isso Moraes esse mundão lindo que a Gente tem tá bom Um grande abraço e até a próxima